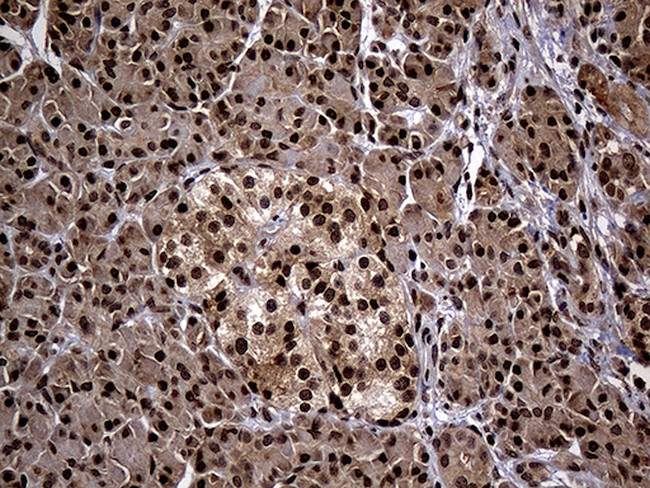
PSMA7 Antibody in Immunohistochemistry (Paraffin) (IHC (P))

Search
OriGene
PSMA7 Monoclonal Antibody (OTI5F6), TrueMAB™
{{$productOrderCtrl.translations['antibody.pdp.commerceCard.promotion.promotions']}}
{{$productOrderCtrl.translations['antibody.pdp.commerceCard.promotion.viewpromo']}}
{{$productOrderCtrl.translations['antibody.pdp.commerceCard.promotion.promocode']}}: {{promo.promoCode}} {{promo.promoTitle}} {{promo.promoDescription}}. {{$productOrderCtrl.translations['antibody.pdp.commerceCard.promotion.learnmore']}}
产品信息
CF810347
种属反应
宿主/亚型
分类
类型
克隆号
抗原
偶联物
形式
浓度
规格
纯化类型
保存液
内含物
保存条件
运输条件
产品详细信息
For reconstitution, we recommend adding 100 µL distilled water to a final antibody concentration of about 1 mg/mL. To use this carrier-free antibody for conjugation experiments, we strongly recommend performing another round of desalting. (Zeba Spin Desalting Columns, 7KMWCO, 0.5 mL, Product # 89882)
靶标信息
Component of the 20S core proteasome complex involved in the proteolytic degradation of most intracellular proteins. This complex plays numerous essential roles within the cell by associating with different regulatory particles. Associated with two 19S regulatory particles, forms the 26S proteasome and thus participates in the ATP-dependent degradation of ubiquitinated proteins. The 26S proteasome plays a key role in the maintenance of protein homeostasis by removing misfolded or damaged proteins that could impair cellular functions, and by removing proteins whose functions are no longer required. Associated with the PA200 or PA28, the 20S proteasome mediates ubiquitin-independent protein degradation. This type of proteolysis is required in several pathways including spermatogenesis (20S-PA200 complex) or generation of a subset of MHC class I-presented antigenic peptides (20S-PA28 complex). Inhibits the transactivation function of HIF-1A under both normoxic and hypoxia-mimicking conditions. The interaction with EMAP2 increases the proteasome-mediated HIF-1A degradation under the hypoxic conditions. Plays a role in hepatitis C virus internal ribosome entry site-mediated translation. Mediates nuclear translocation of the androgen receptor (AR) and thereby enhances androgen-mediated transactivation.
仅用于科研。不用于诊断过程。未经明确授权不得转售。
篇参考文献 (0)
生物信息学
蛋白别名: alpha-4; epididymis secretory protein Li 276; proteasome (prosome, macropain) subunit, alpha type, 7; proteasome subunit alpha 4; proteasome subunit alpha 7; Proteasome subunit alpha type-7; Proteasome subunit alpha-4; Proteasome subunit RC6-1; Proteasome subunit XAPC7; RP5-1005F21.4; testicular tissue protein Li 151; unnamed protein product
基因别名: C6; C6-I; HEL-S-276; HSPC; PSMA7; RC6-1; XAPC7
UniProt ID: (Human) O14818, (Mouse) Q9Z2U0
Entrez Gene ID: (Human) 5688, (Mouse) 26444, (Rat) 29674